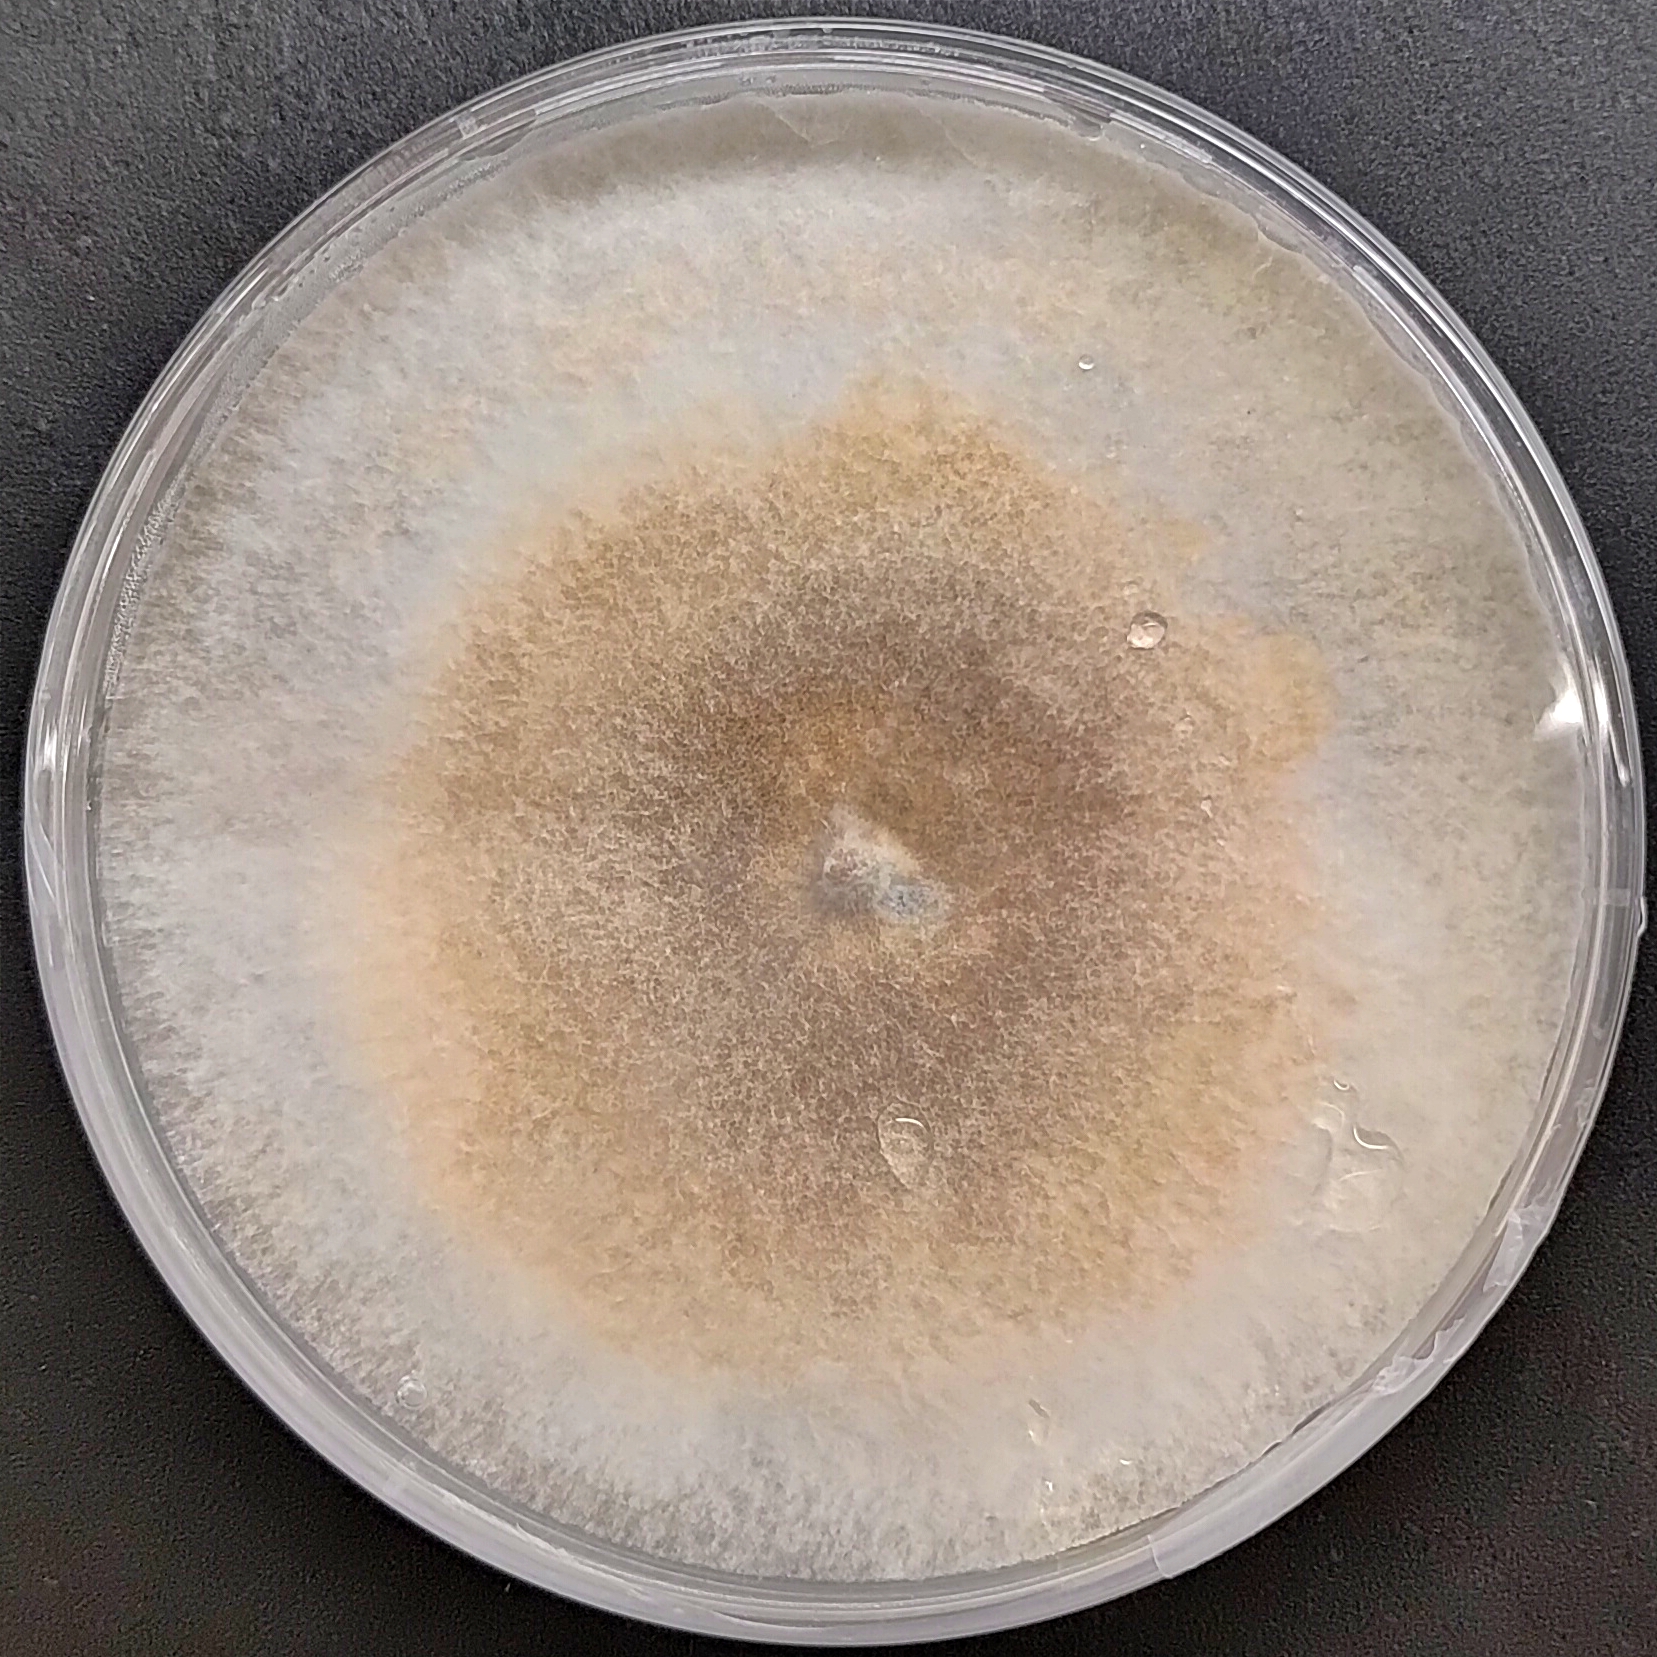
Enoki Mushroom Pure Culture (Flammulina velutipes)

Blue Oyster mushroom culture (Pleurotus columbinus)
₹2,000.00
You’re now subscribed to price tracking for this product. We’ll notify you if the price drops.
Grow the visually stunning and highly productive Blue Oyster mushroom (Pleurotus columbinus) with this professionally prepared pure culture plate. Known for its steel-blue caps during early stages and vigorous colonization, this cold-tolerant strain is perfect for cool-weather cultivation and commercial production.
Whether you’re expanding to grain spawn or maintaining cultures in the lab, this clean, fast-growing strain is ideal for both beginners and advanced mushroom growers.
Product Details:
-
🧫 Format: Sterile 90 mm agar plate
-
🌱 Strain: Pleurotus columbinus (Blue Oyster)
-
❄️ Storage: Refrigerate at 4-8°C; best used within 12 months of label.
-
📦 Packaging: Triple-wrapped, insulated, and clearly labeled for safe transit
-
✅ Best For: Grain spawn creation, liquid culture, cloning, or master culture storage
Strain Highlights:
-
Bold blue caps during early development, fading to grey with maturity
-
Rapid colonization and high yields
-
Performs exceptionally well on straw, sawdust, and paper waste
-
Ideal for colder climates or winter growing cycles
-
Strong mycelial network with rhizomorphic structure
Fruiting Conditions:
-
🌡️ Temperature: 10–20°C (50–68°F), prefers cooler ranges
-
💧 Humidity: 85–95%
-
💡 Light: Indirect natural or 12-hour grow light cycle
-
🌬️ Fresh Air Exchange: 3–5 times daily for optimal cap formation and color retention
Handling Notes:
This is a live fungal culture. Practice sterile techniques when transferring or expanding the culture to ensure clean growth and avoid contamination.
| Weight | 0.1 g |
|---|
Only logged in customers who have purchased this product may leave a review.

Reviews
There are no reviews yet.